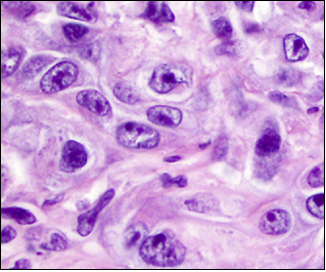
fh染色是什么意思妇瘤新视野丨FH缺陷型子宫平滑肌瘤 vs. 遗传性平滑肌瘤病和肾细胞癌综合征，附2则病例及文献复习_https://www.jmylbn.com_新闻资讯_第11张

审校:何玥 吴玉梅(首都医科大学附属北京妇产医院妇瘤科)
子宫肌瘤是女性生殖系统常见的良性肿瘤之一,多见于30~50岁女性。近年来,随着分子生物学的进展以及对基因诊断相关认识的增加,延胡索酸水合酶(Fumarate hydratase,FH)缺陷型子宫肌瘤逐渐走入临床医生的视野。本团队近一年诊治了4例FH缺陷型子宫肌瘤患者,其中两例为子宫肌瘤复发后再次手术的患者。本文回顾性分析这两例患者的临床及病理特征,并对FH缺陷型子宫平滑肌瘤、遗传性平滑肌瘤病和肾细胞癌综合征(Hereditary Leiomyomatosis and Renal Cell Carcinoma,HLRCC)进行文献复习。
患者1:女性,26岁
未婚,有性生活史,G0P0,因“经量逐渐增多近2年,下腹部可及包块3个月”就诊于我院,月经量多致贫血,血红蛋白最低达64 g/L。否认慢性病、药敏史及传染病史,其母患“子宫肌瘤”病史,否认其他恶性肿瘤家族史。
入院后妇科检查:子宫不规则增大,如孕16周,质硬,活动欠佳。
经腹超声:子宫体大小约9.0 cm×11.3 cm×11.3 cm,肌层回声不均,子宫体部可见低回声结节,大小约8.5 cm×9.8 cm×9.2 cm;CDFI示周边及内部见条状血流信号,挤压宫腔。
拟诊“子宫肌瘤”,结合患者年龄,遂行开腹子宫肌瘤剔除术。术中见子宫球形增大如孕16周,后壁肌壁间肌瘤直径约12 cm,质软,界限不清,肌瘤深达粘膜。手术剔除肌瘤后病理报告为子宫富于细胞型平滑肌瘤。建议术后定期复查。

距首次手术后3个月,复查超声见子宫体大小约6.7 cm×7.0 cm×6.0 cm,肌层回声不均质,后壁突向宫腔见低回声,范围约2.5 cm×1.8 cm×1.6 cm;CDFI示周边及内部均可见点条状血流信号,宫腔居中,可疑子宫肌瘤复发。

距首次手术后半年,复查超声见子宫体大小约6.3 cm×7.1 cm×6.1 cm,肌层回声不均质,后壁为著,后壁突向宫腔见低回声,范围约2.2 cm×2.5 cm×1.9 cm;CDFI示周边及内部均可见点条状血流信号,宫腔受压前移,子宫内膜厚1.2 cm,回声不均。结合临床病史,考虑子宫肌瘤复发。
以“子宫肌瘤剔除术后14个月,子宫肌瘤复发11个月”再次返院就诊,盆腔增强磁共振成像(MRI)提示:子宫体大小约7.4 cm×6.8 cm×8.0 cm(含病变),子宫肌瘤大小约5.0 cm×4.8 cm×4.6 cm,突入宫腔,其内多发囊变,考虑子宫粘膜下肌瘤。

遂行宫腔镜下粘膜下肌瘤切除术。术中见子宫后壁一肌瘤结节,质硬,直径约4 cm,突向宫腔约70%。术后病理提示子宫粘膜下平滑肌瘤,免疫组化提示FH表达水平减弱。接下来对患者进一步行外周血及肿瘤组织二代测序,均检出第3外显子错义突变,提示患者为FH缺陷胚系突变。
第二次手术后3个月,复查超声见子宫体大小约6.4 cm×6.5 cm×6.1 cm,子宫后壁肌层回声不均质,内见非均质回声,范围约5.2 cm×4.4 cm×3.9 cm,内见不规则暗区,较大范围约1.1 cm×1.1 cm×0.8 cm;CDFI内见点状血流信号,宫腔居中。考虑子宫肌瘤二次复发,因患者年轻、未生育,予GnRHa治疗3个月。

距离第二次手术后8个月,复查超声见子宫体大小约6.2 cm×9.6 cm×4.1 cm,肌层回声不均质,后壁可见囊实性回声,范围约8.6 cm×6.4 cm×4.8cm,略压向宫腔,内见不规则暗区,范围约分别为1.3 cm×1.2 cm×0.6 cm、1.2 cm×1.6 cm×0.4 cm;CDFI示周边及内部均可见条状血流信号,宫腔居中。

第二次手术后10个月,复查超声见子宫体大小约5.6 cm×6.6 cm×5.7 cm,肌层回声不均质,右后壁贴近宫腔并大部外突,非均质回声,范围约9.2 cm×7.6 cm×8.8 cm,内见暗区,大小约7.1 cm×5.5 cm×3.4 cm,内见细密点状回声;CDFI示非均质回声,周边可见条形血流信号,宫腔居中。肿瘤标志物CA125为236.5 U/ml。

经与家属商议后,患者坚决要求切除子宫。妇科检查见子宫不规则增大,右侧壁可及外突结节,直径约9 cm。遂行开腹全子宫切除+双侧输卵管切除术,保留双侧卵巢。术中见子宫增大如孕10周,质软,右侧后壁可及外突肌瘤结节,直径约10 cm;剖视子宫见肌壁间肌瘤,结节内可见漩涡结构。
术后病理:子宫静脉内平滑肌瘤病,子宫腺肌瘤,子宫平滑肌瘤。免疫组化:CD31(脉管+),CD34(脉管+),D2-40(脉管+),FH(+),SMA(+)
患者第二次子宫肌瘤切除术后,病理免疫组化提示FH表达水平减弱,对外周血及肿瘤组织进行二代测序,均检出第3外显子错义突变,提示患者为FH缺陷胚系突变。但第三次手术全子宫切除术后,病理免疫组化提示FH(+),考虑原因可能为不同外显子基因蛋白表达不同,或组织发生体系突变可能,且FH的免疫组化检测敏感性并不高,与分子检测符合率在50%~100%,最终诊断仍以基因分子诊断为准。
患者2,女性,29岁
未婚,有性生活史,G2P0,因“多发子宫肌瘤伴尿频半年”于我院就诊,否认慢性病、药敏史、传染病史,否认肿瘤家族史。
妇科检查:子宫增大如孕12周,后壁外突结节,直径约10 cm,前壁外突结节直径约5 cm。肿瘤标志物未查,遂行开腹子宫肌瘤剔除术,术中见子宫不规则增大如孕14周,后壁见一壁间肌瘤结节,质硬,直径约10 cm,右后壁向右阔韧带外突肌瘤结节,质软,大小约6 cm×5 cm×5 cm,前壁下段多个浆膜下肌瘤结节。术中共剔除子宫肌瘤13枚,术后病理示子宫平滑肌瘤,生长活跃。

术后2年,复查超声提示多发子宫肌瘤,最大者直径约6 cm,未行治疗。
术后4年余,自行触及下腹包块,超声提示子宫体大小9.1 cm×10.3 cm×7.0 cm,肌层回声不均,肌壁间可见多个低回声结节,较大位于左后壁,大小约10.1 cm×9.5 cm×8.3 cm,前壁较大结节,大小约4.9 cm×3.7 cm×3.9 cm;CDFI示周边及内部均可见条状血流信号,宫腔受压前移。
盆腔增强MRI提示子宫体明显增大,约9.2 cm×12.3 cm×9.5 cm(含病变),宫腔受压,子宫肌壁、黏膜下及浆膜下见多发结节及肿块(约10个),宫体前壁上段一结节突入宫腔,直径1.3 cm,最大者位于左后壁,大小约7.6 cm×7.9 cm×10.0 cm;DWI多发高信号,考虑子宫富于细胞型肌瘤,血供丰富,生长活跃。
因“开腹子宫肌瘤剔除术后4年余,发现子宫肌瘤复发3年”再次于我院就诊。妇科检查见子宫不规则增大如孕16周,于我院再次行开腹子宫肌瘤剔除术(宫颈肌瘤2枚,子宫腺肌瘤1枚,子宫肌瘤22枚)。术中见子宫增大如孕16+周,表面凹凸不平,子宫后壁宫颈下段可见肌瘤结节一枚,大小约10 cm×10 cm×9 cm,子宫前壁肌壁间外突肌瘤结节一枚,大小约6 cm×6 cm×5 cm,宫底及四壁肌壁间可见多发肌瘤结节。术中剖视子宫可见肌瘤内呈漩涡结构。
术后病理:多发性平滑肌瘤,部分富于细胞,生长活跃,可见核异型、橘红色核仁、嗜酸性小球及鹿角状血管,偶见核分裂象,免疫组化FH(-)。
术后建议患者行基因检测,患者未遵医嘱。第二次手术后半年复查盆腔CT,提示子宫肌层强化不均匀,后壁见低强化结节,约2.5 cm×1.5 cm×1.5 cm。不除外肌瘤复发可能,予GnRHa治疗,现已注射4针,目前仍在随访中。
延胡索酸水合酶(FH)基因位于1号染色体q42.3-q43,参与三羧酸循环中的一系列重要反应,促使细胞利用氧气并产生能量。该基因缺陷是遗传性平滑肌瘤病和肾细胞癌(Hereditary Leiomyomatosis and Renal Cell Cancer,HLRCC)综合征主要致病机制中的关键因素,若FH基因胚系突变,即通过生殖细胞遗传而来,在患者的肿瘤组织和外周血中均可检测到FH基因突变,此类属于HLRCC,又称为Reed’s综合征。此外,还有一种情况,是在非HLRCC综合征的子宫肌瘤患者中,也存在FH基因缺陷,可能参与子宫肌瘤的发病,与HLRCC的主要区别在于FH缺陷型子宫肌瘤是FH基因体细胞发生突变所致,仅限于子宫肌瘤病灶细胞有突变,其余组织没有突变[1],在子宫肌瘤中约占1%。

HLRCC是一种罕见的常染色体显性遗传性疾病,可在人体毛囊周围的平滑肌组织中形成一种平滑肌瘤样变的皮肤(良性)病变,通常形成于手臂、腿部、胸部和腹部,这种良性的平滑肌瘤也可在女性的子宫中表现为肌瘤,这些相应的症状、体征通常在青年-成年期才出现。虽然子宫肌瘤在人群中很常见,但HLRCC患者的子宫平滑肌瘤通常发病早,并且具有肌瘤体积较大、多发、具有细胞异型性的特点。
虽然HLRCC患者的子宫平滑肌瘤生物学为良性,但其罹患肾细胞癌的风险升高约10%~16%,通常发病是在进入中年之后,一般超过40岁,症状及体征主要有腰部疼痛、血尿及查体发现肾部肿物,建议此类患者应纳入肾癌筛查计划。由于HLRCC患者伴发的多为体积较小即可转移的II型乳头状肾细胞癌,故建议使用分辨率较高的MRI进行筛查,以免漏诊。至于HLRCC未合并肾细胞癌的患者,则称为多发平滑肌瘤病(Multiple Cutaneous Leiomyomatosis,MCL)或多发皮肤子宫平滑肌瘤病(Multiple Cutaneous and Uterine Leiomyomatosis,MCUL)。Heikkinen等[2]通过DNA测序和免疫组化未在所有HLRCC综合征患者中检测到FH基因突变,其突变的比例在80%~90%。
目前,FH基因突变的位点与HLRCC的关系仍在研究中,Zhang[3]等通过MSK肿瘤多癌种多基因检测平台检测了7571例癌症患者的胚系基因,其中24例FH c.1431_1433dupAAA(p.Lys477dup)位点突变的患者无一人合并肾细胞癌,且372例肾细胞患者均没有FH c.1431_1433dupAAA(p.Lys477dup)位点的突变,因此得出结论,FH基因的该位点突变与肾细胞癌无关。此研究结论提示,FH突变位点或FH活性水平与表型之间没有明确的相关性,FH基因与子宫肌瘤相关的突变位点仍待于继续探索。
FH缺陷型子宫肌瘤多发于年轻女性,其病理形态学表现为肿瘤细胞具有不典型性,可出现明显的嗜酸性橘红色大核仁、核周空晕、嗜酸性胞质内小球及鹿角状血管,核分裂象偶见。FH缺陷型子宫平滑肌瘤具有特征性的形态学表现,肿瘤细胞具有不典型性,常提示富于细胞,生长活跃,易过诊断为恶性潜能未定的平滑肌肿瘤或平滑肌肉瘤,免疫组化染色示肿瘤细胞FH表达缺失可协助诊断。术后病理提示FH缺陷型平滑肌瘤后,建议密切随访患者,并进一步行分子检测。因FH基因胚系突变具有遗传性,故临床中需注意提醒患者在生育前行遗传咨询,必要时考虑辅助生育或产前诊断,尽可能避免遗传给后代的可能,同时加强肾细胞癌相关筛查。
1. Harrison WJ, Andrici J, Maclean F, et al. Fumarate hydratase-deficient uterine leiomyomas occur in both the syndromic and sporadic settings[J]. AMJ Surg Pathol, 2016, 40: 599-607.
2. Heikkinen T, Äyräväinen A, Hänninen J, et al. MED12 mutations and fumarate hydrataseinactivation in uterine adenomyomas[J]. Brit J Cancer, 2016, 114: 1405-1411.
3. Zhang L, Walsh MF, Jairam S, et al. Fumarate hydratase FH c.1431_1433dupAAA (p.Lys477dup) variant is not associated with cancer including renal cell carcinoma[J]. Hum Mutat, 2020, 41(1):103-109.
吴玉梅,主任医师、二级教授、博士生导师,首都医科大学附属北京妇产医院妇瘤科主任。
学术兼职:中华医学会妇科肿瘤分会委员、北京医学会妇科肿瘤学分会副主任委员、北京妇产学会外阴阴道疾病分会副主委、北京医学会肿瘤学分会委员、中国老年医学学会妇科分会会长。
主要研究方向:宫颈癌放射敏感及放射抵抗机制、妊娠合并宫颈病变的筛查策略、妇科恶性肿瘤的预防。
科研成果:发表妇科肿瘤相关SCI论文30余篇,中文核心期刊论文100余篇;主持国家基金、省科技重点研发项目等多项,获省部级科技奖3项,国家发明专利1项。
个人荣誉:全国医德标兵、北京市先进工作者、北京市三八红旗奖章等。